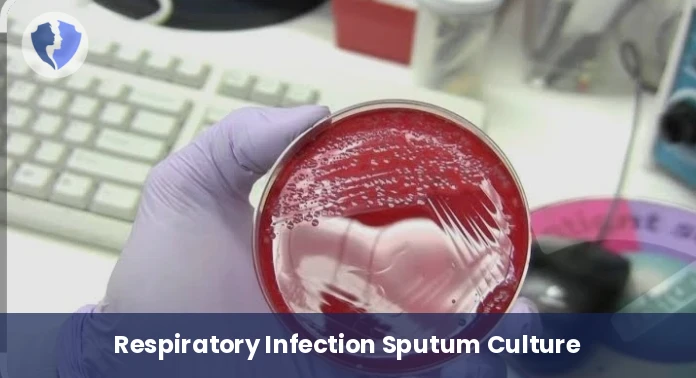
Sputum Culture Test - Sputum Culture and Sensitivity

Service Details
Sputum Culture Test - Sputum Culture and Sensitivity
A comprehensive diagnostic package for lower respiratory tract infections. This includes microscopic examination of a sputum sample to assess its quality, followed by culture on specialized media to isolate and identify the causative microorganisms (bacteria such as pneumococci, Pseudomonas, and fungi). It also includes antimicrobial susceptibility testing of the isolated bacteria to determine the most appropriate antibiotic for treatment.